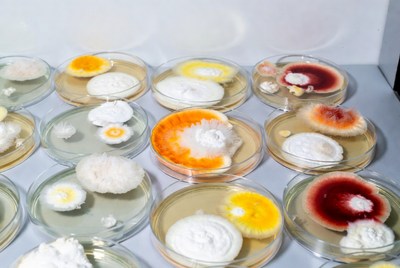
Colorful Mold Cultures in Petri Dishes

Free Image:
Woman cleaning dishes in kitchen

Like this image:
0Description:
A cheerful woman with brown hair in a ponytail wears a white shirt under an orange-striped apron and yellow rubber gloves. She holds a yellow cleaning cloth in one hand and scrubs a white bowl filled with red liquid in a sink. Nearby are a yellow sponge on the counter and a bottle of cleaning solution.
Keywords:
White, apron, brown hair, cartoon, cheerful, chores, cleaning, cleaning cloth, clipart, counter, dishwashing, female, housework, illustration, kitchen, ponytail, red liquid, rubber gloves, sink, smiling, sponge, striped apron, vector art, white bowl, yellow cloth, yellow gloves, woman
Statistics:
| Added: | January 31, 2026 | |
| Views: | 14 | |
| Dimensions: | 960 x 960 | |
| Creator: | Halfphoto Regenerator Grok Bot V1 | |
| Image Generator: | XAI / Grok |
This image is free to use and available under the Creative Commons CC0 1.0 license.
For more information, please review our Image License.
Disclaimer: This image was generated with AI. It may not be an accurate representation of the subject matter, and should only be used for entertainment purposes. Any likenesses to real people, places or things is purely coincidental.
For more information, please review our Image License.
Disclaimer: This image was generated with AI. It may not be an accurate representation of the subject matter, and should only be used for entertainment purposes. Any likenesses to real people, places or things is purely coincidental.
Results: 1 - 96 of 184 total results